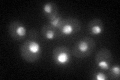
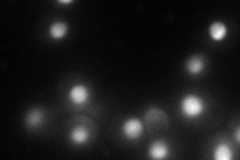
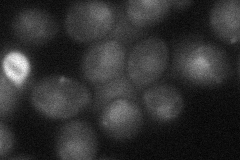
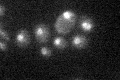

View description
Nuclear exosome exonuclease component; has 3'-5' exonuclease activity; involved in RNA processing, maturation, surveillance, degradation, tethering, and export; has similarity to E. coli RNase D and to human PM-Sc1 100 (EXOSC10)
Localization:
Intensity:
Fold change:
Significance:
-
C’ GFP library in SD
nucleus46.05 -
N' NOP1pr-GFP in SD
nucleus101.211 -
N' TEF2pr-mCherry in SD

nucleus66.6768 -
N' NATIVEpr-GFP in SD

nucleus,nucleolus46.214 -
N' TEF2pr-VC and Cyto-VN in SD
nucleus29.0051 -
C’ GFP library in SD+DTT

nucleus37.520.81No -
C’ GFP library in SD+H2O2

nucleus46.721.01No -
C’ GFP library in Starvation Media
nucleus24.280.52Yes -
C’ GFP library on the background of Pup2-DaMP

nucleus -
C’ GFP library on the background of CCT mutant

nucleus53.01951.15113No
